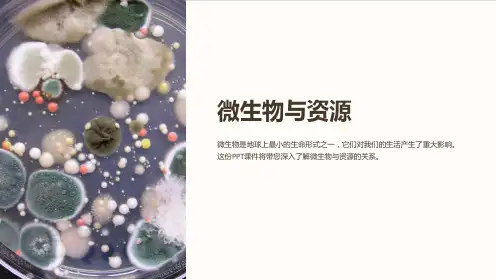

微生物资源的一般特点及开发利用基本原理 38页PPT文档
- 格式:ppt
- 大小:5.15 MB
- 文档页数:38









微生物基础知识ppt课件目录CONTENCT •微生物概述•微生物的形态与结构•微生物的生长与繁殖•微生物的遗传与变异•微生物的生态与环境•微生物的分类与鉴定01微生物概述定义微生物是一类形体微小、结构简单、必须借助显微镜才能观察到的低等生物体的总称。
分类根据形态和结构,微生物可分为细菌、真菌、病毒、原生动物和藻类等几大类。
特点微生物具有体积小、比表面积大、代谢旺盛、繁殖快、易变异等特点。
功能微生物在自然界中发挥着重要作用,如参与物质循环、促进生物地球化学循环、降解有机污染物等。
微生物的研究历史与现状研究历史微生物学的发展经历了漫长的过程,从列文虎克用显微镜发现微生物到巴斯德提出疾病的微生物理论,再到科赫建立纯培养技术,微生物学逐渐发展成为一门独立的学科。
研究现状随着生物技术的不断发展,微生物学的研究领域不断扩大,涉及到环境、医学、农业、工业等多个领域。
同时,微生物资源的开发和利用也受到了广泛关注,如利用微生物生产抗生素、酶制剂、有机酸等。
02微生物的形态与结构细菌的基本形态球菌、杆菌、螺旋菌细菌的结构细胞壁、细胞膜、细胞质、核质特殊结构荚膜、鞭毛、菌毛、芽孢010203真菌的基本形态真菌的结构特殊结构酵母菌、霉菌、大型真菌菌丝、孢子、细胞壁、细胞膜、细胞质、细胞核菌丝体、菌核、子实体010203病毒的基本形态:球形、杆形、砖形、蝌蚪形等病毒的结构:核酸(DNA或RNA)、蛋白质外壳特殊结构:包膜、刺突03微生物的生长与繁殖80%80%100%提供微生物合成细胞物质和代谢产物的碳素来源。
主要用于合成蛋白质、核酸等含氮物质。
维持细胞渗透压、酸碱平衡及酶的活性等。
碳源氮源无机盐水分细胞的主要组成成分,参与代谢反应。
生长因子某些微生物生长所必需的微量有机物质。
温度影响微生物体内生化反应的速率和酶的活性。
pH值影响细胞膜的通透性和酶的活性。
氧气好氧微生物需要氧气进行呼吸作用,厌氧微生物则需要在无氧环境下生长。